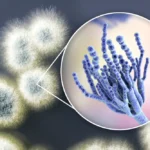

#1 Rated Mold Detection & Removal Services in Markham. Schedule your Free Mold Inspection Via Video Call Today.
FREE MOLD INSPECTION VIA VIDEO CALL*
Book your appointment today!
Mold Removal & Remediation Markham
If you want to get rid of Mold as quickly and safely as possible, Call ☎️ 647-985-2739 now to get a free Mold consultation. Let us help you maintain a healthy, Mold-free environment !
Get a Free Mold Removal Quote in Markham today! We are #1 top rated experts in mold removal & mold testing solutions. We also provide Best mold inspection services. Call us now!
Our highly skilled and certified IICRC mold removal specialists provide efficient and effective mold testing. We ensure eliminating all the dangerous spores and the root cause of it, starting from buildings to homes and other precious possessions. We also sometimes refer to third-party experts such as hygienists and inspectors to double-check the environment’s cleanliness. This helps us provide permanent control of no future conflicts, ensuring you and your loved one’s safety.
We understand your needs. It is our job. We can provide a complete estimate, including photos, to the agent or Adjuster within 24-48 hours.
Our commitment to excellence includes you, which means you can expect effective and ongoing communication and report from us. Each independently owned and operated Ultimate Mold Crew Office works with environmental professionals (IEPs) and laboratories in an effort to protect you and your family from potentially dangerous mold situations.
Mold removal professionals in Markham are trained and ready to mitigate mold losses and meet all challenges with professionalism, reliability, compassion, and respect.
All of our products are 100% eco-friendly so that you and your family are well taken care of. Need mold removal in Markham? No worries we also provide services in Toronto GTA region including Markham, Mississauga , Brampton and surrounding areas too.
⭐ HIRE A MARKHAM MOLD REMOVAL SPECIALIST. CALL US TODAY ☎️ 647-985-2739
Certified Mold Removal Services In Markham
With our 10 years of experience and award-winning mold removal services you get the best facilities from small to large mold remediation projects, grow ops and mold in attics we take care of everything. Our licensed team focuses on the entire building, our aim is to fully end mold from your area so that you and your family can enjoy life at its fullest. Our team makes sure our customers are satisfied and guaranteed quality work.
Best mold removal experts in Markham & nearby areas
Our Markham Mold Removal & Remediation Services Include:
– *Free Mold inspection*s Markham
– Cold Room/Cold Storage Mold Removal Markham
– Bedroom Mold Removal
– Attic Mold Removal Markham
– Kitchen Mold Removal Markham
– Plaster Mold Removal
– Foundation Mold Removal
– Window Mold Removal
– Bathroom Mold Removal Markham
– Crawlspace Mold Removal
– Basement Mold Removal Markham
– Ceiling Mold Removal
– Drywall Mold Removal
– Concrete Mold Removal
Best Mold Removal Service In Markham
– Deep cleaning – We treat mold-damaged property like it is our own. Ultimate Mold Crew’s mold removal experts use the latest technology to identify both mold and the source of moisture that feeds it.
– Continuous Communication – We keep you informed at every step of the cleaning process to make sure everyone involved understands what is happening and what to expect.
– Certified Mold Removal Specialists – Ultimate Mold Crew technicians are fully screened, insured, and exceptionally qualified to remedy property damage.
– Latest Technology – UMC professionals first identify the extent of the problem and then work carefully and sensitively to rescue the affected area and restore it to normal conditions.
We offer:
– Complete mold removal
– Deodorization
– Cleaning and sanitation of the structure, accessories and content
– Containment in the affected area (s)
The Ultimate Mold Crew Inc. knows the importance of having a healthy, mold-free home. Contact us today so we can help you with all your mold removal needs in Markham!
Mold Inspection, detection & expert removal Markham ontario
Mold Inspection & Removal in Markham
Some of the most common questions asked by residents based in & near Markham.
HOW LONG DOES MOLD REMOVAL TAKE?
The length of the mold removal process varies depending on the situation and the size of the affected area. If the mold is confined to a small, localized area, it may take a day to remove. If the mold is in several areas of the house or the affected area is large enough it may take 2-4 days to remedy.
Whenever mold removal is complete, containment enclosures, as well as negative air and air cleaners, are left in place for an additional 24-48 hours. This ensures that all existing mold spores are killed and thorough air exchange is completed. During an inspection with The Ultimate Mold Crew, we will be able to provide you with a specific framework for your project and define the number of days the process will take. This will allow you to be able to plan properly and have complete knowledge of the entire process.
HOW TO REDUCE MOLD GROWTH?
There are a few steps in which you can reduce the risk of mold growth. These are common stocks that a homeowner can take, but are not 100% collateral solutions.
Keep the humidity as low as you can – no more than 50% – all day. An air conditioner or dehumidifier will help keep the level low. Keep in mind that humidity levels change over the course of a day with changes in air humidity and air temperature, so you will need to check the humidity levels. more than once a day Use an air conditioner or dehumidifier during humid months.
Be sure the house has adequate ventilation, including exhaust fans, Bathrooms are cleaned with mold-killing products. Do not carpet bathrooms and basements.
The Ultimate Mold Crew Inc. knows how easy it is to have a mold issue in your home of office. Being a part of the home that is rarely used or visited, small issues that may have been fixed or avoided can be easily overlooked.
If you have concerns that there might be mold in your attic, contact Ultimate Mold Crew Inc for Mould removal and we will send one of our experts to inspect and remove the mold. Our skilled technicians provide excellent removal services at affordable rates in Markham.